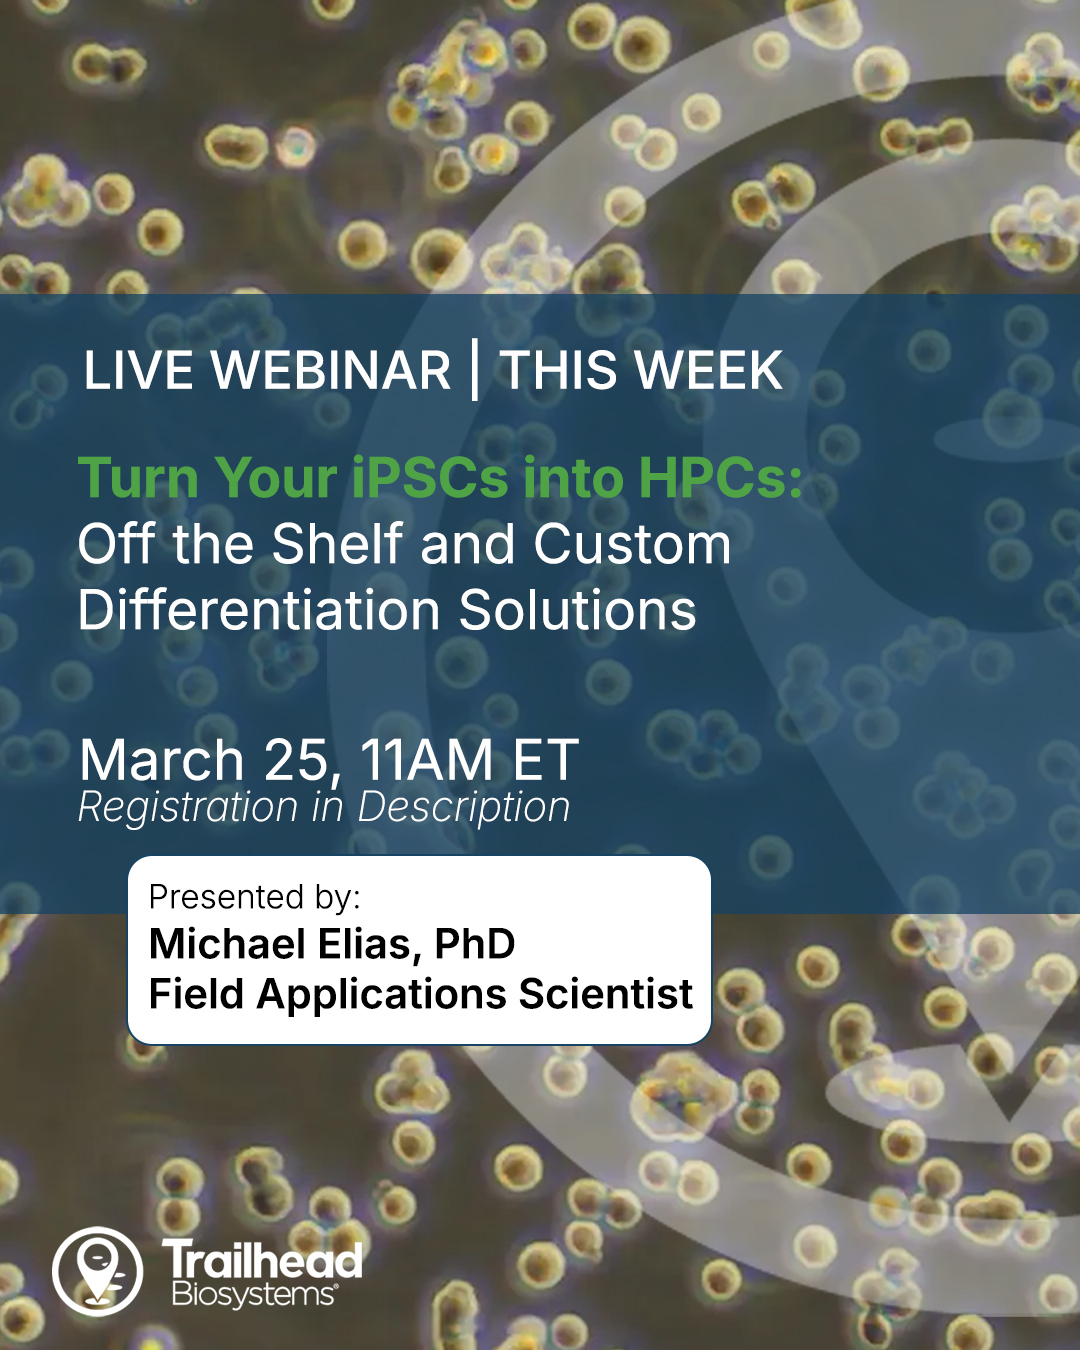

Silesia Challenge 1 za mną! 🥈 Wywalczyłem 2. miejsce w konkurencji mini-rifle z wynikiem 99,56%. Świetne zawody na strzelnicy TAS – zabrakło ułamka do złota, ale forma bardzo cieszy! Dzięki za super rywalizację! 🎯��
#IPSC #MiniRifle #SilesiaChallenge #ZSD #ZSDKrakQTc
1